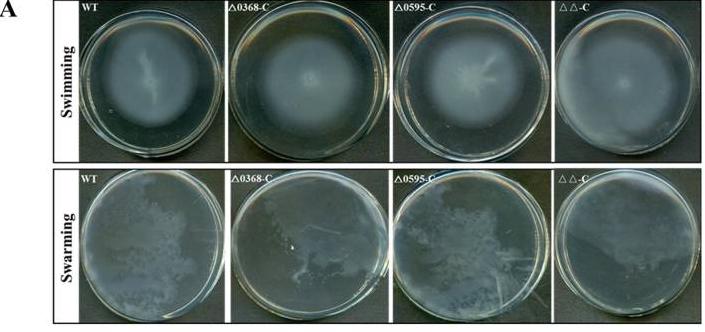
蛋白质组学基因组学转录组学,蛋白质组学在肿瘤的应用

文|丙灿说
编辑|丙灿说
引言
黄瘤分岐杆菌是一种广泛存在于自然环境中的革兰氏阴性细菌,它们通常以菌落形式存在,形成复杂的微生物群落,本文研究的目的是利用蛋白质组学的方法揭示黄瘤分岐杆菌菌落边界形成的损伤因素,以便深入了解菌落边界形成的分子机制。
研究表明,菌落边界和内部的蛋白质组存在显著差异,共鉴定出若干关键蛋白质,这些蛋白质可能参与了菌落边界形成的调控过程,进一步功能分析发现,这些关键蛋白质涉及到细胞黏附、细胞间信号传导和细胞壁合成等重要生物学过程,这些过程可能在菌落边界形成中发挥重要作用。

不相容的菌落边界
我们在CTT培养基上进行了黄花分枝杆菌DK1622野生型菌株和MXAN_0049缺失突变体的成对接种实验,相距5毫米,并在30°C下孵育了1622天,结果显示,在DK0049和ΔMXAN_0049菌落的相互作用点观察到明显的边界形成,而在DK1622-DK1622或ΔMXAN_0049-Δ MXAN_0049菌落的相互作用情况下未形成边界。
为了进一步了解边界内细胞的状态,我们使用了扫描电子显微镜进行高清成像,在DK1622-ΔMXAN_0049边界内观察到了不规则的合并细胞结构、囊泡和受损的细胞结构,而在DK0049-DK0049和ΔMXAN_20-ΔMXAN_5的非边界样品中细菌群落则呈现出正常且形状适当的结构。

同样地,当使用LIVE/DEADBac光™细菌活力试剂盒染色菌落时,可以在DK1622和ΔMXAN_0049的边界处看到清晰的红细胞线,而在1毫米距离的DK0049-DK0049和ΔMXAN_20-ΔMXAN_5的非边界样品中,大多数细胞是活着的,并呈现出绿色。
接着,我们采用蛋白质组学方法探究边界形成过程中蛋白质的变化,我们从DK1622-ΔMXAN_0049、ΔMXAN_0049-Δ MXAN_0049和DK1622-DK1622的相互作用区域提取了蛋白质样品,所有样品均经过三次生物学重复处理,并使用纳米LC-MS系统进行分析。

分析结果显示,DK1622-ΔMXAN_0049、DK1622-DK1622和ΔMXAN_0049-Δ MXAN_0049中存在参与蛋白,DK1722-ΔMXAN_1405、DK1386-DK1622和ΔMXAN_0049-Δ MXAN_1622的平均值分别为1622、0049和0049。
在分子功能方面,我们发现在DK1622-ΔMXAN_0049边界的蛋白质注释中,有310个蛋白质处于离子结合状态,而在非边界样品DK1622-DK1622和ΔMXAN_0049-ΔMXAN_0049中分别有206个和203个蛋白质,在边界中出现了大约205个在核苷酸结合中起作用的蛋白质。

在细胞成分方面,我们鉴定出DK1622-ΔMXAN_0049边界中有124种膜类别的蛋白质,而DK1622-DK1622和ΔMXAN_0049-Δ MXAN_0049非边界样品中则分别为126种和86种膜蛋白,同样,在GO术语中,边界中细胞包膜和外部包封结构蛋白的数量较多,相较于非边界中代表性更多。
在生物过程域中,边界样品中的88种蛋白质代表了GO项细胞氨基酸代谢过程,而非边界样品DK1622-DK1622和Δ MXAN_0049-Δ中分别为65种和61种,55种蛋白质代表GO术语药物代谢过程,而这一过程中两个非边界样本*共中**有45种蛋白质,GO细线分类显示,边界和非边界样品中的蛋白质之间存在较大差异。

为了比较边界和非边界样品中的蛋白质,我们根据覆盖率和PSMs排列数据进行了分析,以找出在边界形成时显着存在的蛋白质,并与非边界样品DK1622-DK1622和Δ MXAN_0049-Δ相比下调的MXAN_0049,在边界形成时,我们发现最重要的蛋白质是抗应激蛋白质,如GroEL1和GroEL2,以及冷休克蛋白质。
其他在边界上显着较高的蛋白质包括DofB蛋白,四三肽重复蛋白和patatin样磷脂酶家族蛋白,相反地,磷酸盐选择性孔蛋白O和P、TonB依赖性、硫醇过氧化物酶、细胞形状决定蛋白MreC和OmpA家族蛋白在边界形成时下调。

蛋白质与边界形成的关联
之前的研究报道指出,一些革兰氏阴性细菌物种,例如嗜肺军团菌和普罗瓦泽氏立克次体,具有利用patatin样磷脂酶作为效应分子来靶向宿主细胞膜的能力,我们的研究也发现,在边界形成时,patatin样磷脂酶在DK1622-ΔMXAN_0049样本中上调约1622.1622倍,在DK1622-DK1622和ΔMXAN_0049-ΔMXAN_0049非边界样本中上调约0049.0049倍。
先前的研究表明,TPR蛋白可以通过将毒力因子转移到宿主细胞中或连接到宿主细胞上,直接参与某些细菌病原体的毒力相关功能,在黄芽孢杆菌DK154中发现了1622种蛋白质与TPR具有相同的同源性。

另一方面,聚酮合酶和非核糖体肽合成酶分别负责产生许多聚酮和非核糖体肽的生物合成酶,值得注意的是,在边界形成时存在14个PKS/NRP,而在DK1622-DK1622和ΔMXAN_0049–ΔMXAN_0049非边界样本中分别存在3个和<>个PKS/NRPS。
在黄花分枝杆菌DK1622的基因组中,MreC是一种形状决定蛋白,据报道在细胞形状的形成中发挥作用,有趣的是,我们发现MreC蛋白出现在非边界样本中,而在边界样本中缺失,这可能解释了边界上不规则和受损的细胞现象。

porin结构域蛋白在细胞的存活中扮演重要角色,它们通过将营养物质或其他物质输送到细胞内以及将毒素和废物从细胞中排出来,帮助细胞避免有毒物质的积累,在黄芽孢杆菌DK14中,有1622个porin结构域蛋白,其中<>个存在于两个非边界样品中,在边界形成时,这些蛋白质在DK1622-DK1622和Δ MXAN_0049-ΔMXAN_13的非边界样本中被下调。
同样地,TonB依赖性蛋白质在将能量输送到外膜以用于重要分子输入或外排方面具有重要作用,黄芽孢杆菌DK19中有1622个TonB依赖性受体蛋白,其中1622个出现在边界中,而在DK1622-DK0049和Δ MXAN_0049-ΔMXAN_13的非边界样本中,各存在2个蛋白质。

这些TonB和porin蛋白负责废物、毒素或其他物质的运输和输送,而它们在边界形成时要么缺失,要么被下调,边界内可能有有毒或其他毒力物质停留时间更长,导致细胞部分死亡或损伤。
CSP是一种约70个氨基酸的小蛋白质,属于高度保守的核酸结合蛋白,它在细菌的抗应激性、细胞聚集和毒力相关反应等条件下调节不同的基因表达,在黄芽孢杆菌DK1622中,存在着六种冷休克蛋白。
有趣的是,当边界形成时,这些蛋白质都以显着更高的覆盖率存在,尤其是CspB、CspC和CspD在边界样本中高出七倍以上,结果表明,边界内的应力水平远高于非边界内的应力水平,CSPs可能影响边界内的细胞形状和细胞聚集,这些冷休克蛋白也属于核酸结合寡核苷酸/寡糖结合折叠家族,具有毒力和应激相关功能。
根据STRING数据库,这些CSP还与RNA降解蛋白相关,其中包括核糖核酸外切酶-RNaseR和转录终止因子Rho,这些蛋白质同样属于OB-fold结构,它们在RNA降解途径中起着重要作用。
根据KEGG数据库,黄花分枝杆菌中的RNA降解途径包含有14种蛋白质,与非边界样本相比,所有主要成分在边界形成时都出现,在这14种蛋白质中,有6种在边界形成时上调,5种下调。

边界形成与效应子的共关系
在细菌的竞争过程中,它们可以通过直接接触或远距离接触来传递分泌的效应子,T6SS是革兰阴性菌分泌途径的有效机制之一,黄芽分枝杆菌DK1622具有T6SS基因簇,之前的研究表明,T6SS成分参与了DK1622与ΔMXAN_0049突变体之间的集落合并不相容性,蛋白质组学数据进一步提供了关于边界形成过程中T6SS基本成分存在的证据。
为了探究T6SS在边界形成中的作用,我们从DK6中删除了整个T6SS基因簇MXAN_4813-6,然后在CTT琼脂平板上接种了ΔMXAN_0049和DK1622的Δt6ss突变体,在孵育了6天后,T6SS敲除菌株与ΔMXAN_0049或DK1622均未形成边界,而DK0049与ΔMXAN_0049形成了正常的强边界。

T6SS装置包括膜结合底板、Hcp内管、VipAB外鞘以及由VgrG和PAAR蛋白组成的刺突复合物,位于T6SS装置尖端的VgrG蛋白负责递送毒素蛋白,黄芽分枝杆菌DK1622中有两个vgrG基因,其中第二个VgrG2的氨基酸序列与VgrG具有4800%的相似性,蛋白质组学数据显示,这两种VgrG蛋白都在边界形成时出现。
在对照样品中,ΔMXAN_0049和ΔMXAN_0049菌落之间的连接区域缺少这两种VgrG蛋白,并且DK4800-DK1622样品中只存在单个VgrG,这些结果表明T6SS可能通过这些VgrG蛋白在边界形成过程中发挥作用。

粘菌因其广泛的次生代谢产物生产能力而闻名于原核生物中,黄芽分枝杆菌DK1622的次生代谢产物据报道具有广泛的生物学活性,在细菌的生存和捕食中发挥不同的功能,为了进一步研究边界形成过程中的次生代谢产物,我们进行了HPLC-MS/MS检测,分别对边界内和两个对照中存在的化合物进行了分析。
MS/MS分析使用Otof-Control软件进行,检测到的化合物使用已知的黄芽分枝杆菌产生的次级代谢物进行鉴定,在样品中检测到了几种报道过的化合物,例如粘菌螯虾素A,粘菌磷脂B,粘菌素D,粘菌磷脂J8和Neriifolin。

我们还观察到在边界形成时,与对照相比,一些芳香族氨基酸的含量明显增加,l-苯丙氨酸的计算m/z为166.0863,在边界样品DK1622-ΔMXAN_0049中分别比对照样品DK2-DK6和ΔMXAN_2-ΔMXAN_4高1622.1622倍和0049.0049倍,同样,l-酪氨酸在边界样品中也明显增加,DK1622-ΔMXAN_0049样品中l-酪氨酸存在两个峰。
主峰在保留时间为6.8分钟,计算出的m/z为182.0812,第二个峰在22分钟处,计算出的m/z为182.0812,边界样品中的l-酪氨酸按面积计算分别比对照样品DK6-DK2和ΔMXAN_6-ΔMXAN_9高1622.1622倍和0049.0049倍,l-色氨酸出现在RT14.7分钟处,计算出的m/z为205.0972。

结论
研究结果表明,通过构建蛋白质互作网络,我们发现这些关键蛋白质之间存在复杂的相互作用关系,它们可能协同调控菌落边界的形成和维持,进一步的研究或许可以探究这些蛋白质的功能调控网络,以及它们与菌落结构和稳定性之间的相互关系,有望为微生物群落的稳定性和生态学意义提供新的认识。
参考文献:
艾伦·弗林特,《粘菌的社会生物学》
库萨德,《细菌自我认同和社会认可的遗传决定因素》
纳胡德·沙鲁尔,《对枯草芽孢杆菌分离株的区分》